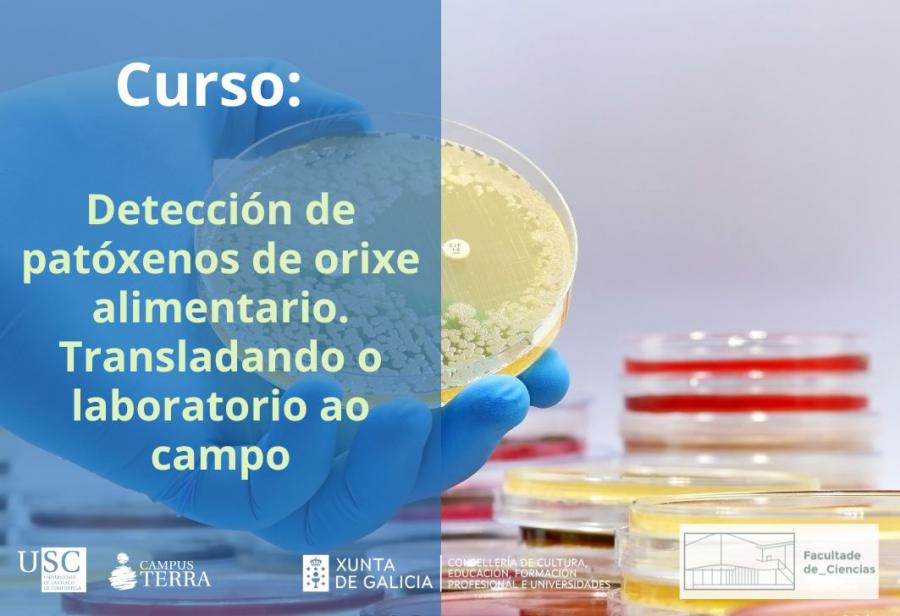
Cartel do curso

Edificio laboratorios
O curso coordinado por Alexandre Lamas desenvolverase o 3 de xuño na Facultade de Ciencias. A inscrición permanece aberta en liña
A Facultade de Ciencias da USC acolle o 3 de xuño a celebración do curso ‘Detección de patóxenos de orixe alimentaria. Trasladando o laboratorio ao campo’, unha proposta formativa coordinada por Alexandre Lamas e impartida por Alejandro Garrido que está incluída no Plan Formativo 2024 do Campus Terra da USC. As persoas interesadas en participar neste curso, orientado a estudantado universitario e tamén a profesionais e axentes do sector produtivo, poden formalizar xa a súa inscrición en liña.
O programa do curso, que se desenvolverá en quenda de mañá, de 9.00 a 14.00 horas, pretende facilitar a transferencia ao sector produtivo de técnicas de microbioloxía dependentes de cultivo e de bioloxía molecular empregadas de rutina nos laboratorios de seguridade alimentaria, ademais de abordar aplicacións prácticas en situación reais.
A temática do programa afondará sobre métodos de microbioloxía dependente de cultivo para a detección de patóxenos na cadea alimentaria e tamén tratará as técnicas moleculares como alternativa máis rápida aos métodos de microbioloxía dependentes de cultivo. Daquela, no curso explicarase de forma teórica e práctica o emprego de técnicas isotérmicas como a amplificación isotérmica mediada por bucle (LAMP, por as súas siglas en inglés). Asemade, tamén se demostrará de forma práctica como estas técnicas poden ser aplicadas na propia industria alimentaria sen necesidade de contar con laboratorios dedicados e con equipamento custoso.
